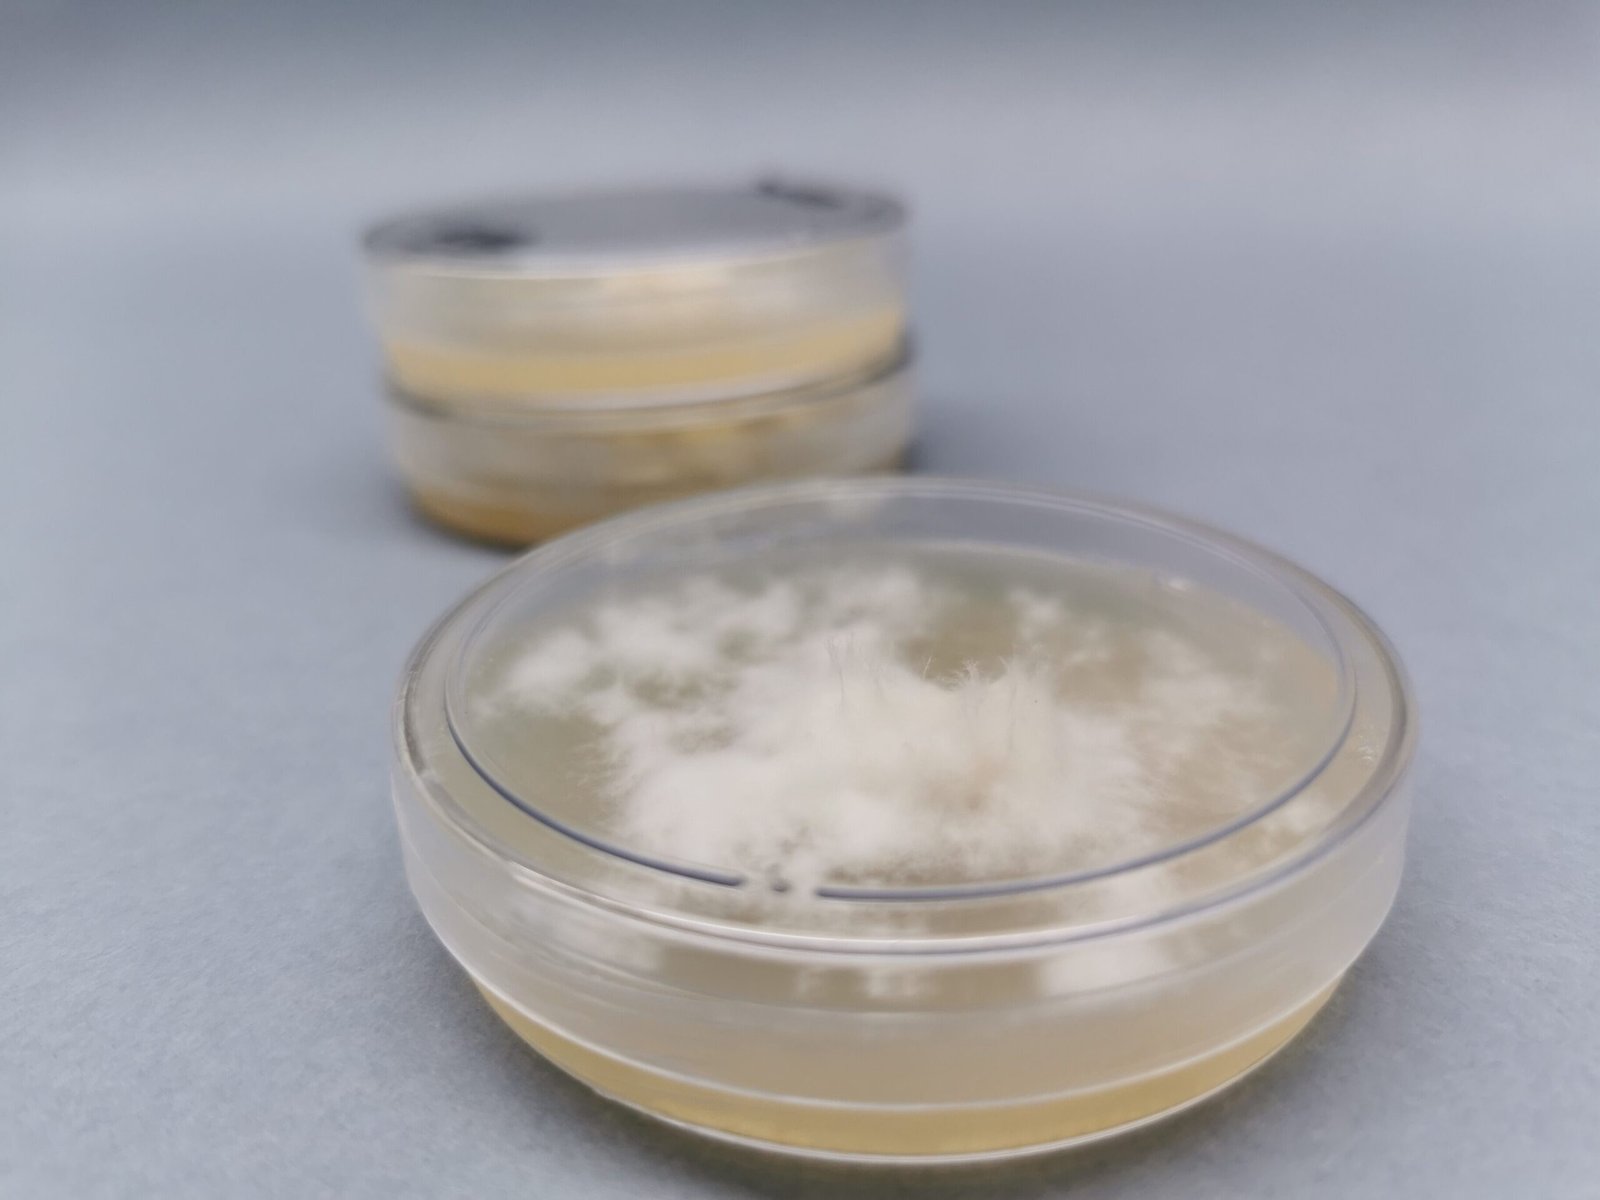

Frete grátis em compras a partir de 400 reais
Descrição do produto
Placa Petri – Hericium erinaceus (Lions Mane)
Sobre
A Placa Petri colonizada é uma das bases do inicio do cultivo de qualquer fungo. Ela é composta por uma solução gelatinosa nutritiva, em que o micélio do fungo utilizará essa gelatina como nutriente para seu desenvolvimento. São selecionados os melhores exemplares de outros cultivos para a sua produção. Para produzir a placa colonizada, é necessário que todo o ambiente esteja asséptico, assegurando assim que não haja contaminação por outros microorganismos. Para garantir a qualidade de nossos produtos, todas as placas são produzidas em câmara de fluxo laminar.
Utilização
A partir da Placa Petri – Hericium erinaceus (Lions Mane), podem ser feitas replicas desta placa em outras placas que ainda não foram colonizadas, produção de cultura liquida do fungo presente nela, e por fim, para a produção do Spawn diretamente da placa. Para mais informações sobre cultivo, acesse nosso blog (clicando aqui) e assim obtenha conhecimento a respeito de diferentes métodos, tanto para iniciantes, quanto cultivadores mais experientes. Além disso, você pode adquirir produtos complementares ao Spawn, como materiais ou insumos (clicando aqui).
Características Gerais
Placa Colonizada
Tamanho: 60 x 15 mm
Armazenamento
O armazenamento deve ser feito sob refrigeração. Sobretudo, armazenar longe de crianças e animais.
História
Quer conhecer mais sobre o Hericium erinaceus (Lions Mane)? Clique aqui
Rede social
© Art Cogumelos • CNPJ 53.884.625/0001-20 • Todos os Direitos Reservados